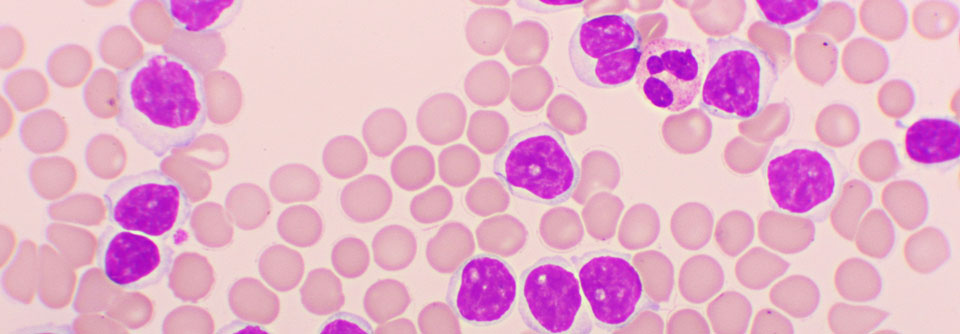

Akute lymphatische Leukämie Es geht voran bei der ALL
Um die Prognose nach einer allogenen hämatopoetischen Stammzelltransplantation (HSCT) zu verbessern, wurden in den vergangenen Jahren einige Bemühungen unternommen. Ein Fokus lag unter anderem auf der Überwachung der minimalen Resterkrankung, die sich als ein signifikanter prognostischer Faktor herauskristallisierte, berichtete Prof. Dr. Ali Bazarbachi, American University of Beirut.
Patient:innen mit positiver MRD vor der Transplantation haben ein höheres Rezidivrisiko als MRD-negative Personen, woraus man schließen könne, dass eine MRD-Positivität vor einer allogenen HSCT behandelt werden sollte. In der BLAST-Studie konnte durch die Gabe von Blinatumomab in rund 80 % der Fälle ein MRD+…
Bitte geben Sie Ihren Benutzernamen und Ihr Passwort ein, um sich an der Website anzumelden.